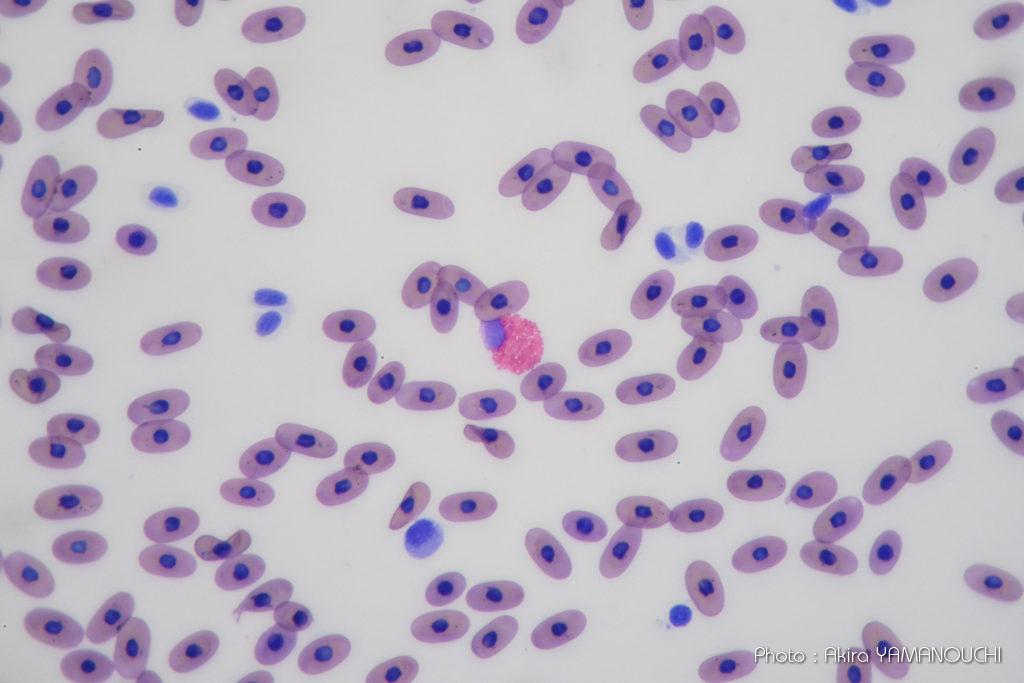
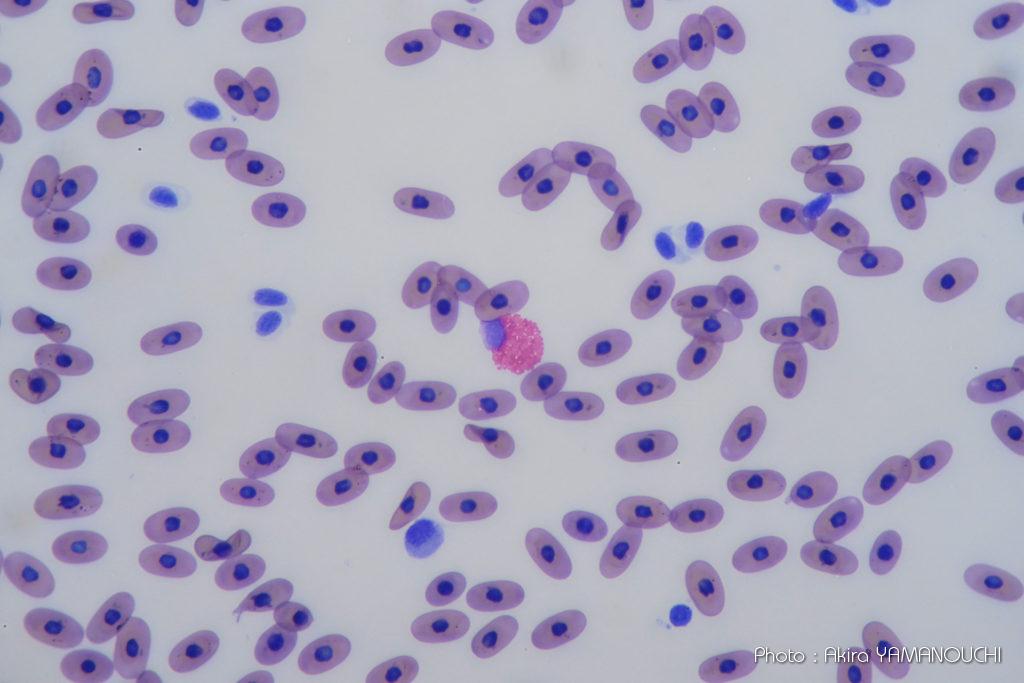
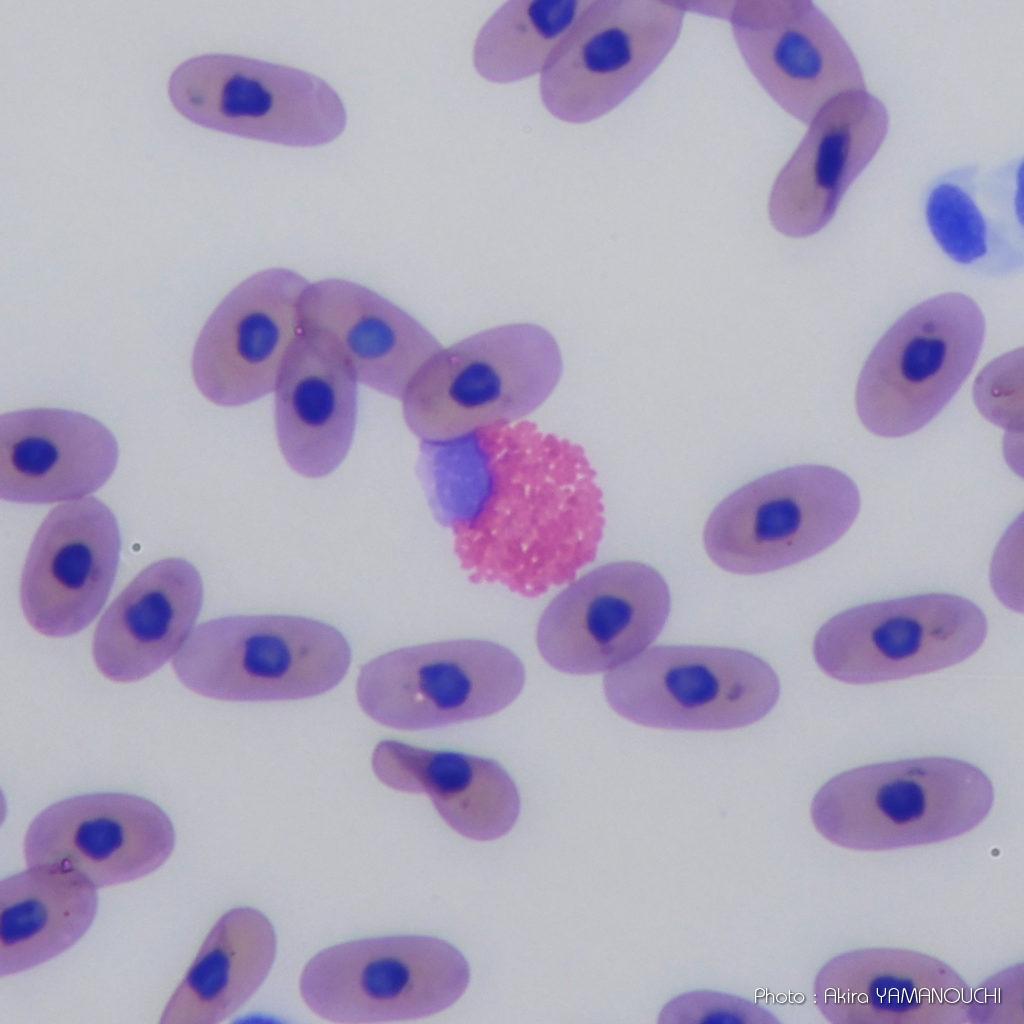
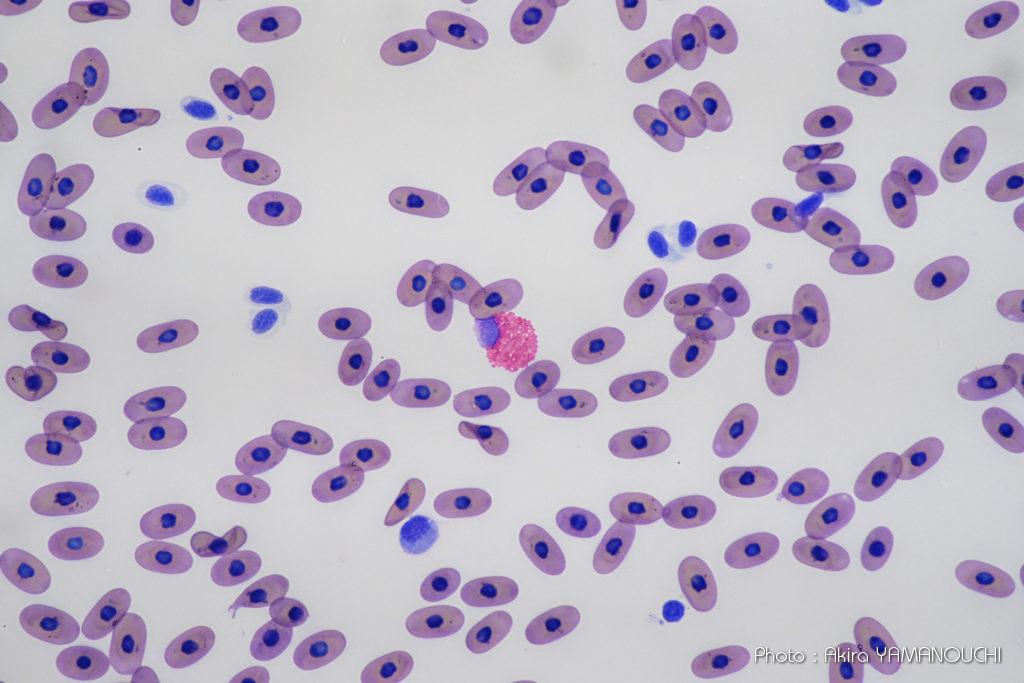
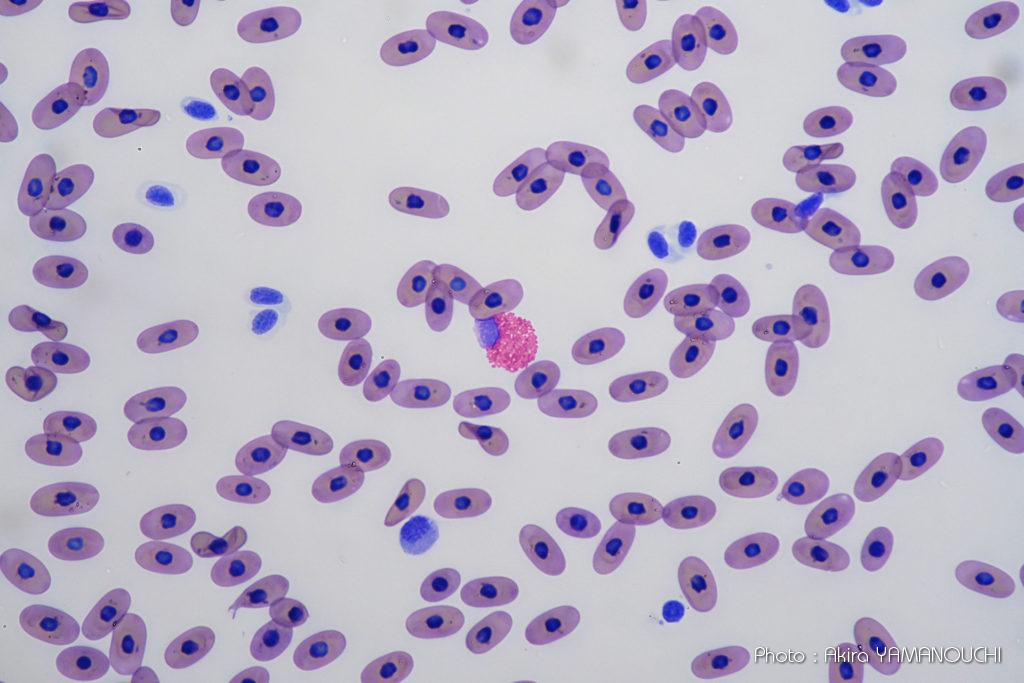
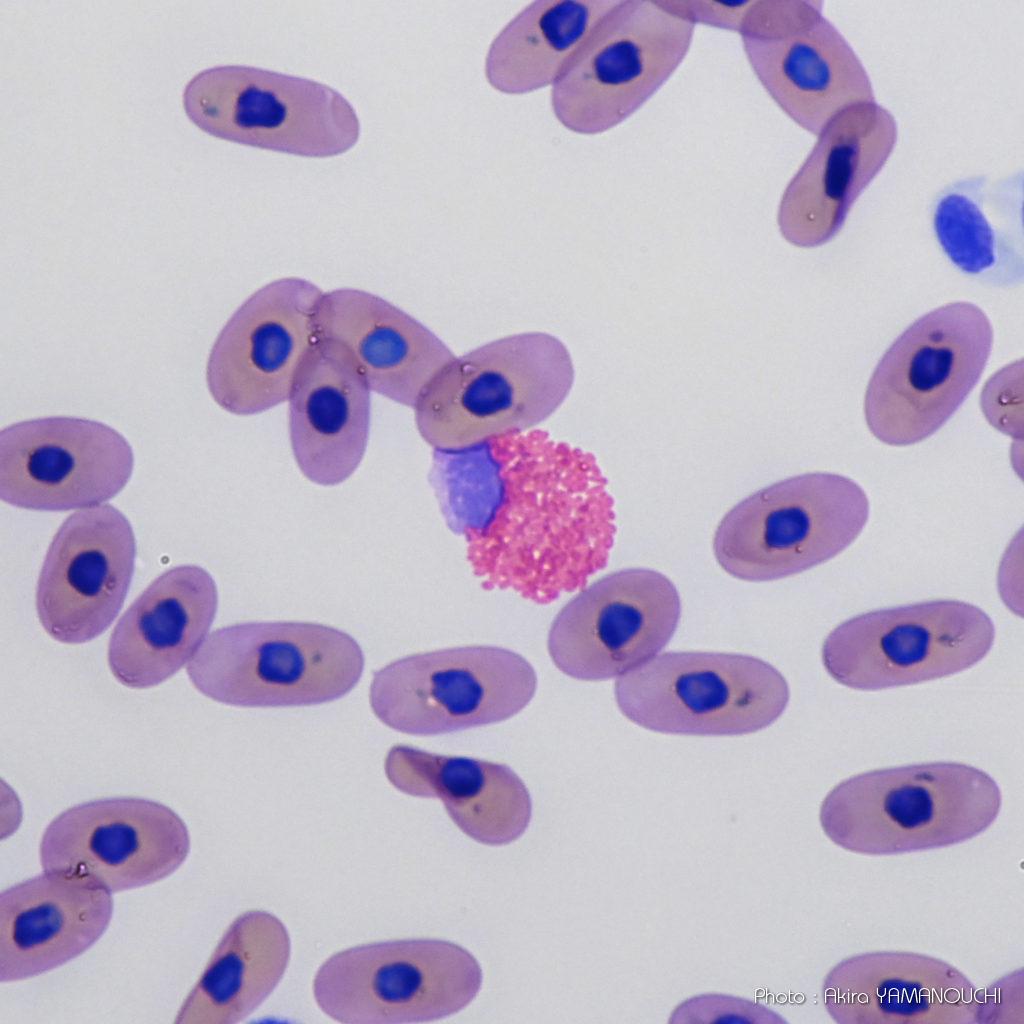
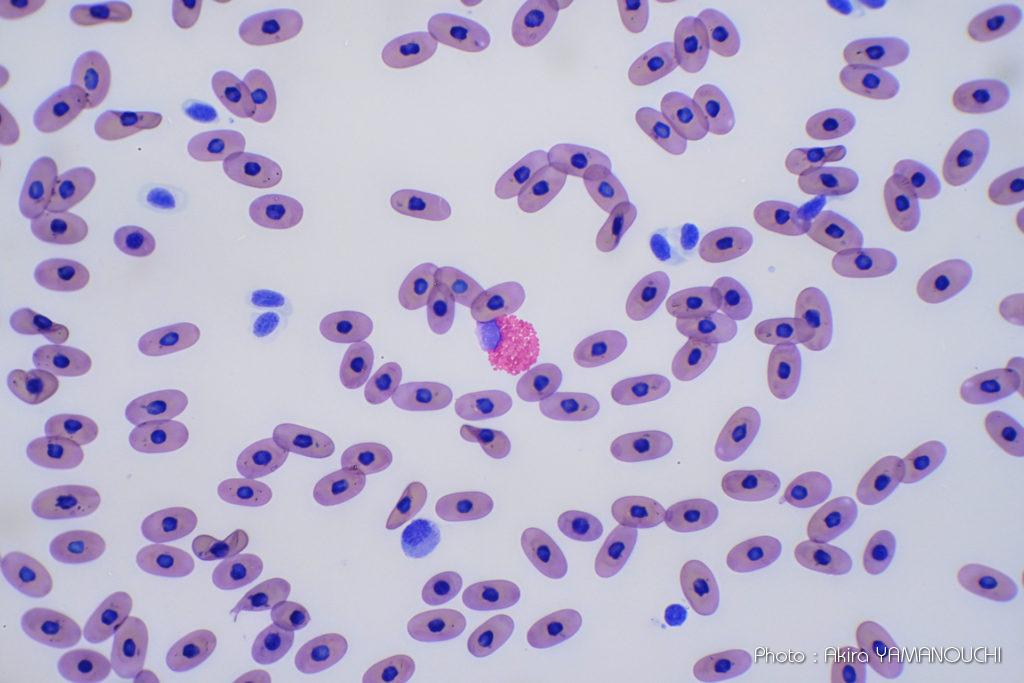
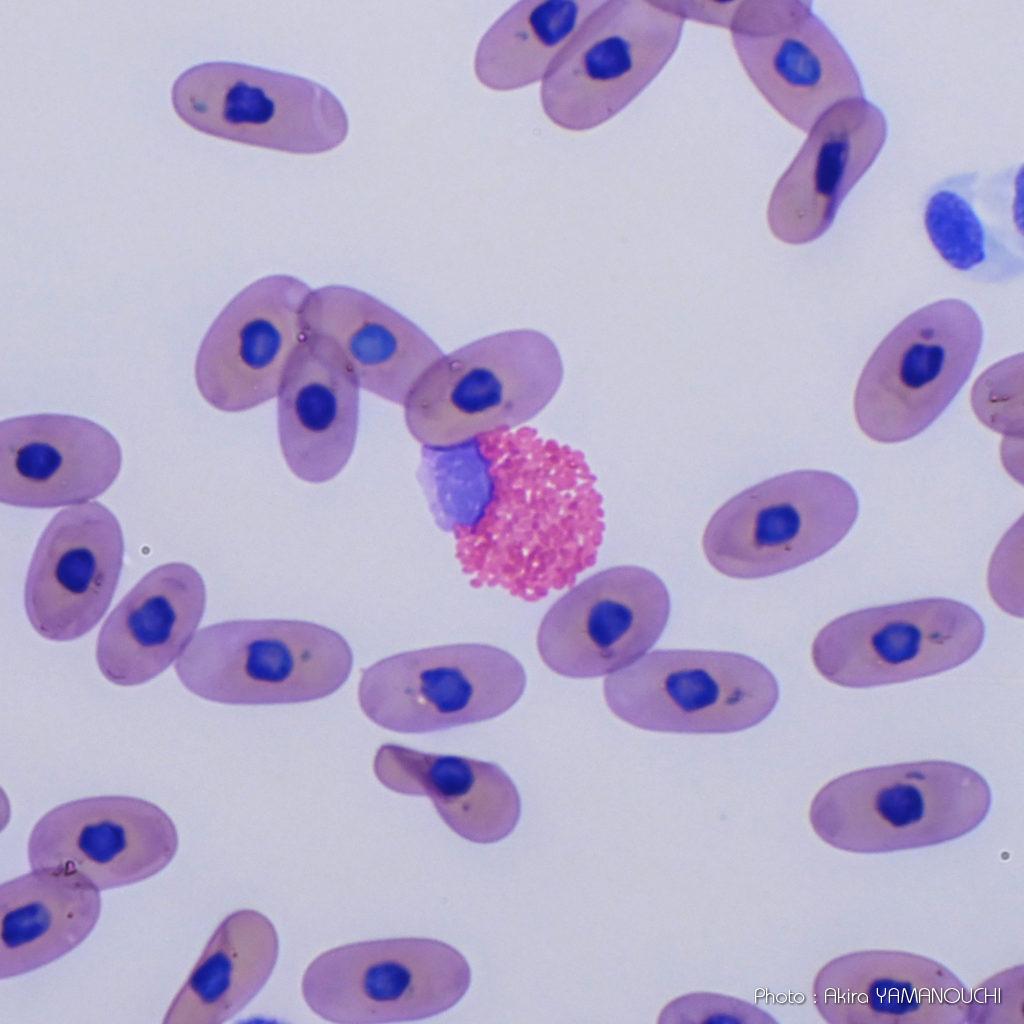
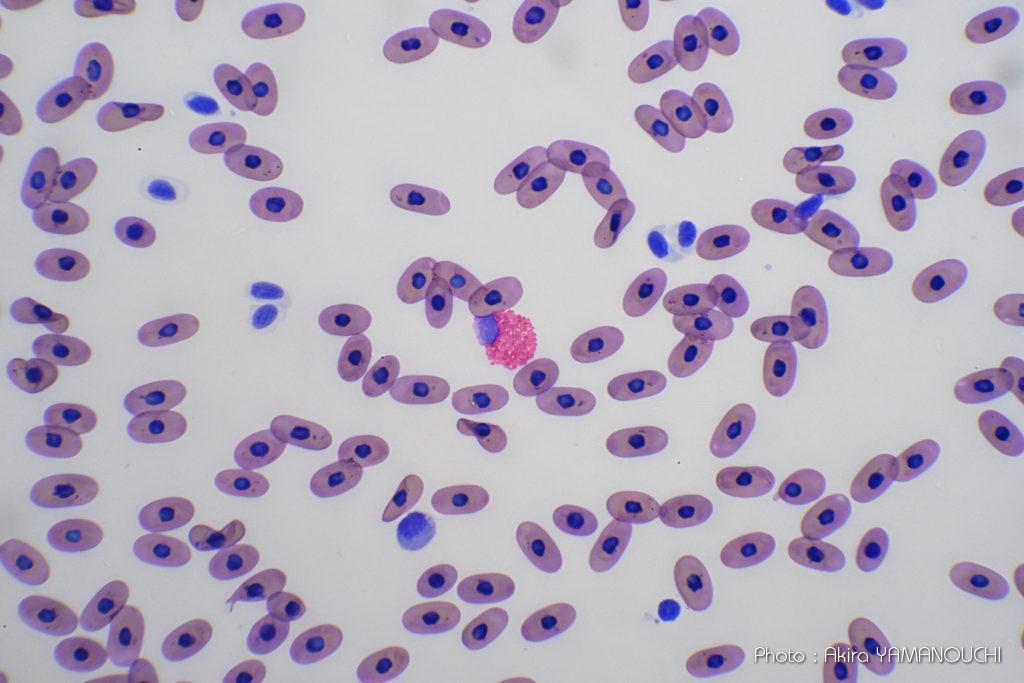
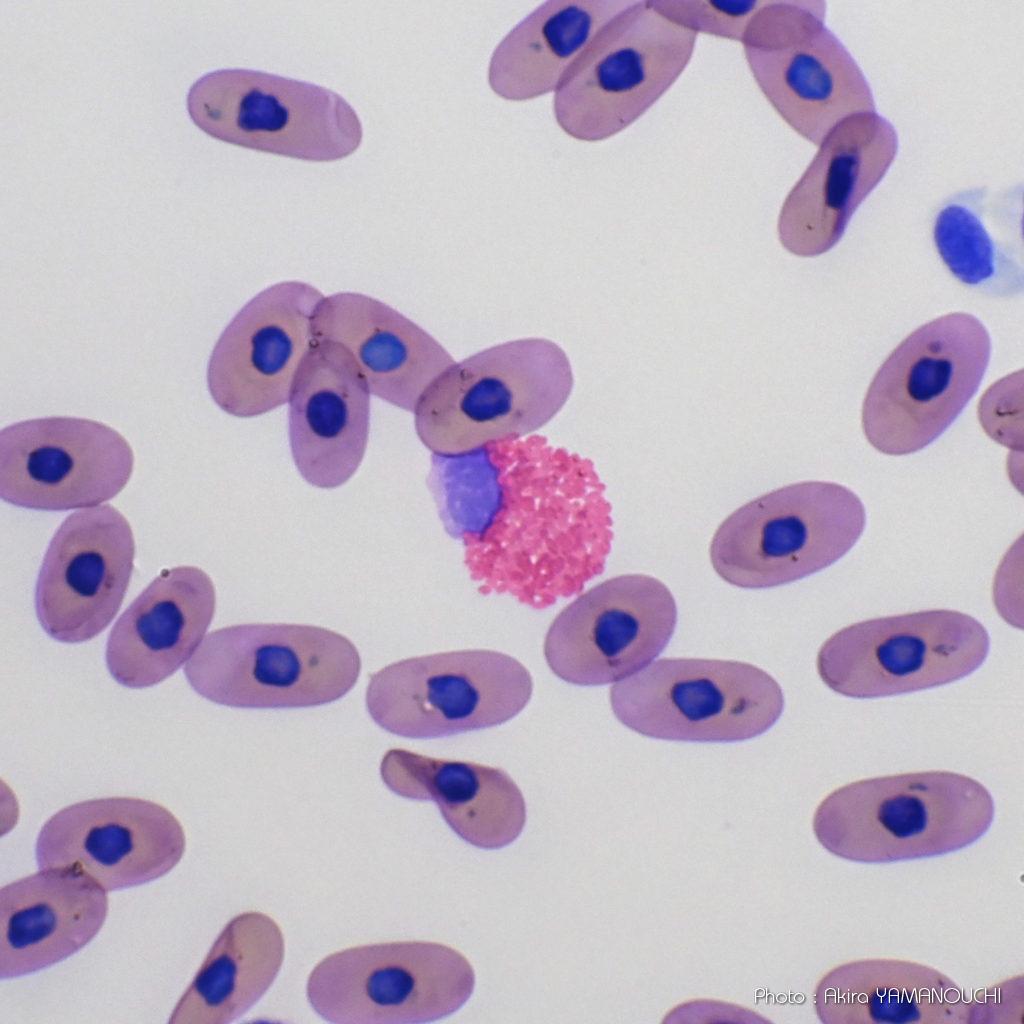

顕微鏡のレンズには様々なグレードがあります。無印のもの、Planと書かれたもの、Fluorと書かれたもの、Apoと書かれたものなどがあります。価格も1本数万円のものから100万円を超えるものまであります。何がどう違うのでしょう。
顕微鏡写真も生業としているため、撮影用の対物レンズを各種揃えています。顕微鏡写真は対物レンズが命なので、こだわりを持って選んでいます。中古で購入したり譲り受けたりした様々なグレードの対物レンズもありますので、具体的な比較画像を撮ってみたいと思います。良く使う倍率で、グレードの差が出やすいのが40倍なので、様々なメーカーの様々な仕様の40倍レンズを比較してみます。顕微鏡購入時の参考になれば幸いです。
いずれも有限遠補正光学系(機械的鏡筒長160mm)の旧式のレンズです。

対物レンズの名称
顕微鏡の対物レンズの歴史は収差との闘いでしたので、その収差補正の種類やグレードによって異なる名称がつけられています。
色収差補正
顕微鏡対物レンズの収差で最も重要なのが色収差の補正です。光は波長の違いによって屈折率が異なるため、白色光をレンズに入れると虹色に分解されて1点に収束しません。白色の点光源は虹色の同心円の像になります。特に顕微鏡の対物レンズは高倍率に拡大するため、色収差の影響が大きくなります。
それを補正するために屈折率と分散率が異なるガラスで作られた凸レンズや凹レンズを組み合わせて可能な限り色収差が出ないように補正します。しかし、現実的な価格ですべての波長の光を1点に収束するレンズを作るのは不可能です。妥協案として何色かの色を1点に集めるように補正して、その色数によってグレード分けしています。
アクロマート(Achromat)
2色に対して色補正を行い、球面収差とコマ収差を最小限にした光学系の名称です。複式顕微鏡では対物レンズの像を接眼レンズで拡大して観察するので、対物レンズの収差はそのまま接眼レンズで拡大されてしまいます。したがって対物レンズは最低でもアクロマートでないと快適な観察はできません。
アクロマートレンズは実習用顕微鏡など、一般的な顕微鏡の対物レンズとして最も使われています。
アクロマートはレンズ構成枚数がアポクロマートよりも少ないためコントラストが高いことがあります。きちんと作られた有名メーカーのアクロマートは被写界深度もある程度確保でき、眼視観察にはこちらの方が優れていることもあります。
表記法はメーカーや時代によっても異なります。Ach、Aなどが使われることもありますが、有名メーカーでは「アクロマートはあたりまえ」なので、何も書かれていないこともあります。後述するPlan系対物レンズはほとんどアクロマートなので、わざわざPlanAchなどとは書かず、Planだけの表記が多いようです。
アポクロマート
3色に対して色収差を行い、球面収差とコマ収差を最小限にした光学系の名称です。最高の硝材と研磨技術によって作られる最高グレードの対物レンズがプランアポクロマートです。顕微鏡メーカーがその時の光学技術の粋を集めて会社の威信をかけて作るレンズなので、1本百万円を超えるものもあります。多くは病理学者などの研究用、撮影用として使用されています。
アポクロマートは省略されることはなく、対物レンズ側面には最高性能の証として誇らしげに刻印されているはずです。Apochromat、Apoなどの表記があります。
セミアポクロマート(フルオリート)
アポクロマートが最高の性能を発揮しますが、あまりに高額となるため、アクロマートとアポクロマートの中間的な色消し度合のグレードが作られました。それをセミアポクロマートと呼んでいます。
アクロマートよりも良く見え、アポクロマートよりも手ごろな価格で買えるので、研究所や医療系大学、病院、検査センターなどで広く使われています。
アクロマートやアポクロマートは屈折率や分散率が異なる硝材を組み合わせた複数の凸凹レンズを組み合わせて色消しを行いますが、そもそも色分散が少ない硝材を使えば、より少ないレンズ構成で色収差を少なくすることができます。
蛍石は極めて分散率が低い硝材であることが発見されました。蛍石を使った顕微鏡対物レンズはフルオリートと呼ばれます。蛍石は望遠鏡やカメラの世界ではフローライトと呼ばれますが、近代の顕微鏡はドイツがリードしてきたので、顕微鏡の世界ではドイツ語読みのフルオリートと呼ばれることが多いようです。フルオリートは硝材の名称で、アクロマートやアポクロマートとは別のアプローチで色消しを行っているものです。
レンズの刻印としては、S.Apoやフルオリートを表すFluorやFLなどと表記されていることが多いようです。
像面湾曲収差補正
像面湾曲収差の補正は、プランと書いてあるかないかの分類しかありません。
無印
プランと書かれていないものは像面湾曲収差の補正がされていません。眼視観測には使えますが、写真撮影には向きません。視野中心にピントを合わせると周辺がボケます。
しかし、眼視観測では視野中心部を集中して見ているためか、網膜が球面のためか、あまり違和感を感じなかったりします。
プラン
像面湾曲収差が補正されたレンズに付けられる名称です。こちらは省略されることなく対物レンズ側面にPlanと刻印されていると思います。プラン系のレンズは、視野中心と周辺でピントのずれがなく、像面がフラットです。写真撮影を行う場合はプラン系レンズを使用します。
対物レンズのグレード
上記色消し度合や像面弯曲収差の補正の有無によって呼称とグレードが分かれます。一般的には次のような表記とグレードに分類されます。
表記 | 像面弯曲 補正 | 色収差補正 | 主な用途 |
無印(倍率のみ) | × | × | おもちゃ |
A、Ach | × | アクロマート | 実習用 |
Plan、PL | ○ | アクロマート | 検査、診断 |
Fluor、FL | ○ | セミアポクロマート | 研究、検査、撮影 |
PlanApo | ○ | アポクロマート | 研究、撮影 |
手持ちの40倍対物レンズ
Olympus
タイプ | 表記 | 倍率 | 開口数 | 補正環 | 備考 |
アクロマート | A40PL※ | 40x | 0.65 | × | 位相差用 |
プランアポクロマート | SPlanApo40 | 40x | 0.95 | ○ |
※A40PLのPLは位相差対物レンズの種類の表記で、Positive Lowを表します。Planを表すPLではありません。
Nikon
タイプ | 表記 | 倍率 | 開口数 | 補正環 | 備考 |
セミアポクロマート | Fluor40 | 40x | 0.85 | ○ | フルオリート |
プランアポクロマート | PlanApo40 | 40x | 0.95 | ○ |
撮影方法

すべて160mmの有限遠補正光学系なので、CH-2のレボルバに取り付け、三眼鏡筒に取り付けたNikon社製Z50にて撮影しました。撮影レンズはOlympus製NFK 3.3X LDです。撮影レンズはOlympusの製品しか持ち合わせていないため、Nikon社製対物レンズの評価は正しくない可能性があります。レンズによっては対物レンズと接眼レンズや撮影レンズとセットで収差補正しているものもあるからです。あらかじめご了承ください。
標本
実写の解像度とコントラストを見たかったので、ミシシッピアカミミガメの血液塗抹標本を使用しました。好酸性の顆粒を持つ白血球が多数観察されたので、同一ターゲットを使用しました。
実写
Olympus製対物レンズ
A40PL

SPlanApo40

Nikon製対物レンズ
Fluor40

PlanApo40

総評
もっと差が出ると思って行った実験でしたが、Olympus、Nikonと言う世界に誇る日本の二大顕微鏡メーカー製なのでどれもよく見えます。比較しなければ何の不満もなく実用になるでしょう。
しかし、比較するとOlympus、Nikonともプランアポクロマート系のレンズは素晴らしく、完璧な描写が得られます。色収差は完全に補正されているようで縁が彩られたりすることはありません。
また、中央部から周辺までピントが合ったフラットな写真が撮れます。プラン系ではない単純なアクロマート対物レンズでも中心像は問題なく使えるレベルです。
A40PL SPlanApo40
Fluor40 PlanApo40
上は各レンズによる画像を比較のために必要以上に強拡大したものです。普段はこのような使い方はしませんが、ここまで拡大すると各レンズの性能の差が見えてきます。
プラン系ではない単純なアクロマートレンズでも、OlympusやNikonなどのメーカーがきちんと製造しているものは分解能も高く、眼視観測ではほぼ違いが判らない程度です。重箱の隅をつつくためにここまで拡大して比較することによってはじめて像の甘さが見えてくる程度です。40倍で顆粒球の顆粒がここまで分解できていれば十分です。
プランアポクロマートはOlympus、Nikonともやはり素晴らしい性能を発揮します。顆粒球の顆粒の数や形状まで分解しています。どちらも開口数0.95で、乾燥系対物レンズでは最大の数字です。開口数は、アクロマートでは0.65、フルオリートでは0.8となっています。
NikonのFluor40は思いのほか分解能が高く、プランアポクロマートに勝るとも劣らない性能です。年代が分からないので、単純な比較はできませんが、かなりこだわりを持って作ったレンズであることがうかがえます。また、補正環があるレンズはカバーガラス厚に応じて球面収差を補正するために調整を行います。可能な限り調整しましたが、補正環の調整不足による分解能の違いかもしれません。
いずれにしても、プラン系のセミアポクロマート、アポクロマートレンズは、アクロマートレンズとは一線を画する分解能であり、写真撮影用としては優れた性能を発揮します。
眼視観測でしたら、有名メーカーの顕微鏡であれば、アクロマートレンズで十分であることも分かります。


Amazon Link |
---|
![]() |
顕微鏡撮影の必需品:ML-L7 これがないと顕微鏡撮影はできないと言えるほど必須アイテムです。 静止画や動画のボタンの他、モニターの拡大・縮小や十字キーまで備えられているので、位置決めとフォーカシング以外、カメラや顕微鏡に触れることなく顕微鏡撮影ができます。ブレから解放されます。 |
![]() Nikon Li-ionリチャージャブルバッテリー EN-EL25 Amazon |
![]() Nikon FTZ II Amazon |
![]() 【Nizon Z50 専用】 2枚セット 超薄ガラス液晶保護フィルム Amazon |
![]() ProGrade Digital SDXC UHS-II V60 GOLD 128GB Amazon |
![]() Prograde Digital(プログレードディジタル) SD UHS-II Amazon |
![]() ProGrade Digital SDXC UHS-II V60 GOLD 512GB Amazon |
![]() Lexar SDカード 256GB Professional 1800x SDXC Amazon |
![]() NIKKOR Z DX 16-50mm f/3.5-6.3 VR Amazon |
![]() NIKKOR Z 24-120mm f/4 S Amazon |
![]() NIKKOR Z 24-50mm f/4-6.3 Amazon |
![]() NIKKOR Z 24-70mm f/2.8 S Amazon |
![]() NIKKOR Z 24-70mm f/4 S Amazon |
![]() NIKKOR Z 20mm f/1.8 S Amazon |
![]() NIKKOR Z 50mm f/1.2S Amazon |
![]() NIKKOR Z 85mm f/1.2S Amazon |
![]() NIKKOR Z MC 105mm f/2.8 VR S Amazon |
![]() NIKKOR Z 135mm f/1.8 S Plena Amazon |
![]() NIKKOR Z DX 50-250mm f/4.5-6.3 VR Amazon |
![]() NIKKOR Z 100-400mm f/4.5-5.6 VR S Amazon |
![]() NIKKOR Z 180-600mm f/5.6-6.3 VR Amazon |
![]() NIKKOR Z 400mm f/2.8 TC VR S Amazon |
![]() NIKKOR Z 800mm f/6.3 VR S Amazon |
![]() Z TELECONVERTER TC-1.4 Amazon |
![]() Z TELECONVERTER TC-2.0 Amazon |
![]() ニコン マウントアダプターFTZII Amazon |